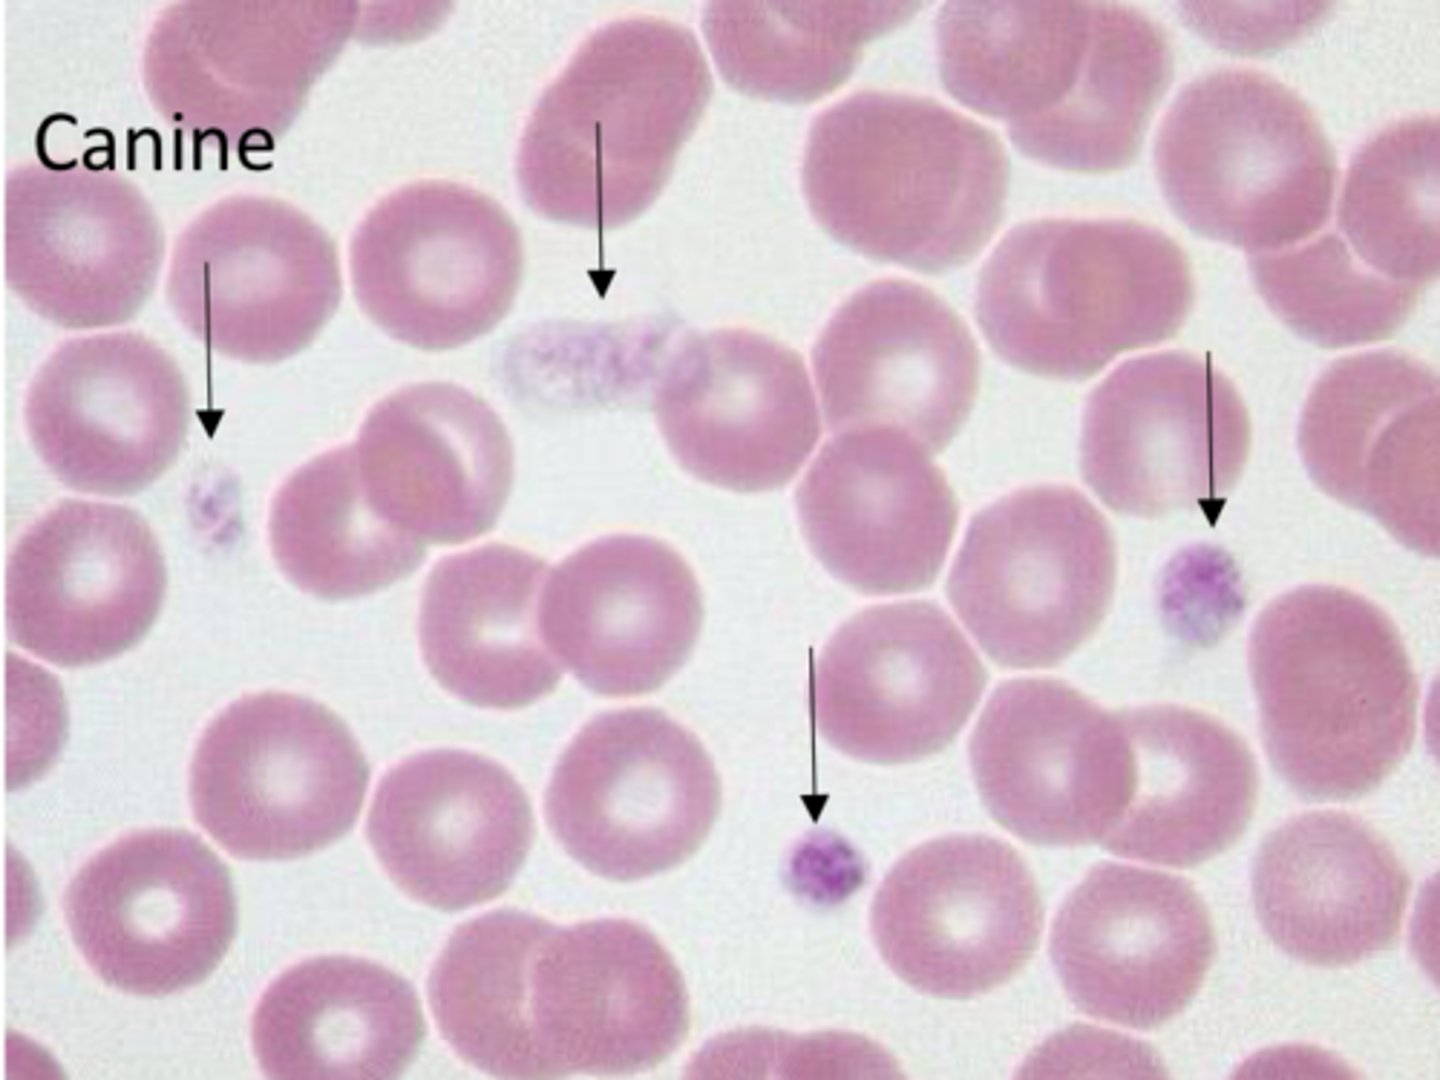
<p>What are characteristics of platelets in mammals?</p>

1/43
Looks like no tags are added yet.
Name | Mastery | Learn | Test | Matching | Spaced | Call with Kai |
|---|
No analytics yet
Send a link to your students to track their progress
Identify if the following is a cause of Hypocoagulation or hyper coagulation?
Endstage DIC?
Hypocoagulation
Identify if the following is a cause of Hypocoagulation or hyper coagulation?
Liver failure
Hypocoagulation
Identify if the following is a cause of Hypocoagulation or hyper coagulation?
Viperidae envenomation
Hypocoagulation
Identify if the following is a cause of Hypocoagulation or hyper coagulation?
Vit K deficencies
Hypocoagulation
Identify if the following is a cause of Hypocoagulation or hyper coagulation?
Sepsis
Hypercoagulation
Identify if the following is a cause of Hypocoagulation or hyper coagulation?
Protein losing nephropathy
Hypercoagulation
Identify if the following is a cause of Hypocoagulation or hyper coagulation?
Endocrine disorders like DM or cushings
Hypercoagulation
Identify if the following is a cause of Hypocoagulation or hyper coagulation?
Severe anemias
Hypercoagulation
Under normal conditions the body will be ____ and ____?
Anti-coagulable - preventing clots
Profibrinolytic - break down clots fast
Laminar flow
What will we see in primary hemostasis?
Platelets
Petechation
What are characteristics of platelets in mammals?
Anucleate
Blue cytoplasms
Reddish cytoplasmic granules

What are characteristics of thrombocytes in non-mammals?
Round dense nucleus
Clear cytoplasm
Found in clumps
What is the in the phospholipid bilayer of a platelet>
Glycoproteins for activation adhesion and aggregation
How are platelets made?
Megakaryocytes break off
What is the life cycle of a platelet? What animals are they typically circulating for longer?
3-9 days
Splenictomized animals
Where is thrombopoietin produced? What will enhance its production?
Liver
IL-6 inflammatory
What is going to initiate coagulation?
Vascular inj stimulating Tissue factor expression on sub endothelial cells
What are the 4 steps of Primary hemostasis?
Platelet Adhesion
shape change
granual secretion
aggregation
What things might a platelet release in its granules?
ADP
Serotonin
Fibrinogen
Factor V (5)
Factor XI (11)

What are some things that could cause pseudothrombocytopeina?
Clumping - dramatic collection, improper handling/ EDTA
Macroplatelets
Given the following values from blood smear calculate the number of platelets for a dog?
5, 5, 4, 6, 5, 5, 4, 8, 5, 6
(5 + 5 + 4 + 6 + 5 + 5 + 4 + 8 + 5 + 6) / 10 =5.3
5.3 * 15,000 =79,500/uL
Given the following values from blood smear calculate the number of platelets for a cat?
5, 5, 4, 6, 5, 5, 4, 8, 5, 6
(5 + 5 + 4 + 6 + 5 + 5 + 4 + 8 + 5 + 6) / 10 =5.3
5.3 * 20,000 =106,000 /uL
What breed is predisposed to macrothrombocytopeina?
Cavalier king Charles - increased size of platelets
What will you see on CBC of macrothrombocytopenia?
Total platelet mass (plateletcrit) - normal
Giant platelets (High MPV)
Low platelet count
Name a few clinical signs of primary hemostasis?
Petechiae
Gingival bleeding
Hematuria
Melena
Epistaxis
What are 4 main causes of thrombocytopenia?
Splenic sequestration
Decreased production
Increased consumption/ utilization
Increased destruction
What are causes of splenic sequestration?
Splenic congestion - neoplasia/ heat stroke (uncommon)
What is the main cause of decreased production primary hemostasis?
Bone marrow panhypoplasia (decreased megakaryocytic)
-drugs (estrogen/ chemo)
-Toxins
-Radiation
What are infectious causes of decreased production primary hemostasis?
Erlichiosisi
FeLV
EIA
BVD
What are causes for platelet utilization/ consumption?
Trauma
Thromboembolic dz
Viperidae envenomation
Hemangiosarc
DIC
What is Primary immune mediated thrombocytopenia (ITP)?
Circulating platelets/ megakaryocytic destroyed by immune mediated mechanisms - Platelets numbers dramatically reduced
What Breeds do we typically see ITP?
Cocker spaniels
Toy poodles
If we see a normal platelet number on CBC but have evidence of bleeding/ clotting disorders what two things might we suspect?
Thrombocytopathy - impaired function
Deficiency in vWF
What is von willebrands factor used for?
Platelet adhesion to collagen
What breeds typically get VWD?
Doberman pinschers
What is Glanzmann thrombasthenia?
Defect in platelet aggregation due to genetic GPIIb/IIIa deficiency (Can't bind to fibrinogen)
Buccal mucosal bleeding time test is contraindicated in what pts?
Thrombocytopenic pts - no additional info collected
When would a buccal mucosal bleeding time (BMBT) test be indicated?
Normal platelet count w/ concurrent clinical signs of primary hemostatic disorders
When will we see a prolonged (over 4mins) BMBT test?
Thrombocytopenia
vWD
Thrombopathy
What are the two most common tests for vWD?
Elisa
Immunoelectrophoresis
What is the cause of physiologic Thrombocytosis?
Epinephrine induced splenic contraction -> increased number of circulating platelets
What is the cause of reactive or paraneoplastic thrombocytosis?
Inflammation or tumor production of IL-6 which stimulates TPO release -> increased platelet production
What is recovery from thrombocytopenia?
Rebound response causing increased bone marrow megakaryocyte production
What nutritional deficiency can occasionally cause thrombocytosis?
Iron deficiency